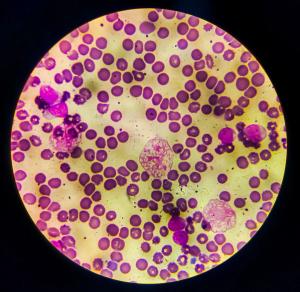
Acute lymphoblastic leukemia -- Image credit: Arif Biswas | stock.adobe.com

This abstract will be presented at the Oncology Pharmacists Connect (OPC) meeting in Austin, Texas, from June 19 to 20, 2025.

This abstract will be presented at the Oncology Pharmacists Connect (OPC) meeting in Austin, Texas, from June 19 to 20, 2025.

Delayed pegaspargase reduces hepatotoxicity without affecting outcomes.

Leukemia biology may predict patterns of blinatumomab failure after initial response.

The significant surge in oncology drug shortages in 2023 particularly affected essential chemotherapeutic drugs.

A single-center experience at a tertiary medical center precision medicine clinic provides insight.

Pharmacists will play a significant role in TKI adherence rates among patients.

Published: April 21st 2025 | Updated:
Published: January 30th 2025 | Updated: